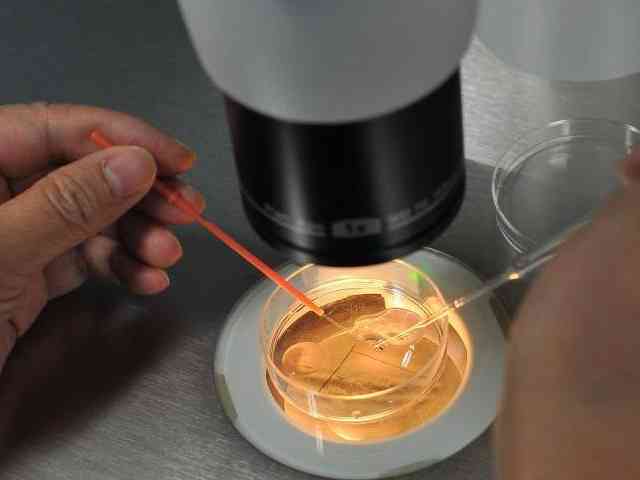

青苹之末
宫寒的女性还不少,引起宫寒的原因可能与女性生活习惯、饮食习惯有一定的关系,宫寒的危害有很多,不仅会影响女性的身体健康,而且还会导致女性出现不孕的情况,女性需要多了解一些女性宫寒不孕的知识,对宫寒不孕的症状有一定的概念,争取尽早发现尽早治疗。

一般来说,宫寒不孕属于是女性宫寒疾病中比较严重的一种,引起宫寒不孕的原因,可能是女性自身的生理原因,也可能是生活习惯、饮食习惯等原因,还有可能是妇科疾病,也容易引起女性宫寒,宫寒不孕的症状主要有4种,其具体内容如下:
在日常生活中,有部分女性很容易手脚冰凉,特别是在入秋以后,不管穿多厚的衣服都缓解不了女性手脚冰凉的症状,这属于是典型的宫寒症状,由于女性身体虚弱,气血运行不畅所引起,手脚冰凉的症状在宫寒不孕女性中很常见;
宫寒不孕女性,一般月经前小腹会有坠胀感,并且出现白带增多、腰酸背痛、两乳胀痛等现象,除此之外,少数女性会有反胃、作呕的反应,经期有时会错后,月经色淡而量少,女性精神较差,平时腰酸腿软,而且小便较多,月经量少;

通常情况下,腹部受寒冷所影响,会有时作痛、小腹发凉、月经颜色黑并有血块,个别女性会有严重的痛经症状;
宫寒女性患者还会浑身发胖,并且伴随着气短乏力、失眠多梦、不排卵的症状,由于女性子宫热量不足,子宫越是冷,身体就越需要囤积脂肪来御寒,进而引起女性发胖。
四代试管
卵巢早衰交流群三代试管
优生优育攻略群高龄生子
绝经助孕攻略群无精/死精
显微取精交流群冷冻卵子
生育力保存经验群出国生子
海外试管交流群大家在看